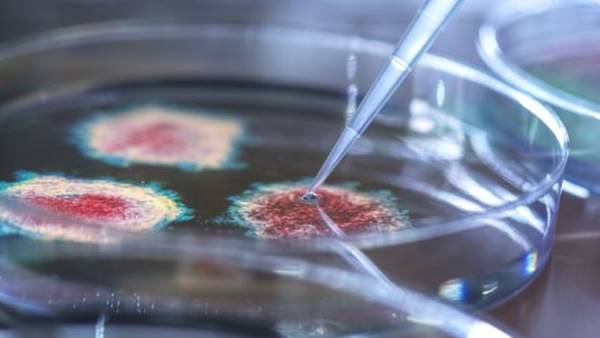
கவலை

ஓவர் ஸ்பீடு.. மொத்தம் 29 நாடுகளில் பரவிய ஒமிக்ரான்.. 373 பேருக்கு பாதிப்பு.. அதிர்ச்சி தகவல்
29 நாடுகளில் ஒமிக்ரான் பரவி உள்ளதாக கூறப்படுகிறது
கேப்டவுன்: உலகம் முழுவதும் 29 நாடுகளில் பரவிய ஒமிக்ரான் பாதிப்பு ஏற்பட்டுள்ளதாக கூறப்படுகிறது.. இதையடுத்து மற்ற நாடுளிலும் இந்த வைரஸ் தொற்றின் கவலை சேர்ந்து கொண்டுள்ளது.
தென்ஆப்பிரிக்காவில் முதன்முறையாக ஒமிக்ரான் வகை கொரோனா பாதிப்பு கண்டறியப்பட்டது. இந்த ஓமிக்ரான் வைரஸ் உலகெங்கும் பீதியை கிளப்பி கொண்டிருக்கிறது..
இதனை தொடர்ந்து பல்வேறு நாடுகளுக்கும் பரவ தொடங்கியுள்ளது. இது மிக வீரியமிக்கது என்றும், பன்மடங்கு பெருகும் சக்தி கொண்டது என்றும் விஞ்ஞானிகள் சொல்கிறார்கள்.
கவலை
டெல்டா வைரஸ் போலவே தாக்கத்தை தந்துவிடுமோ என்ற கலக்கமும் உலக மக்களை சூழ்ந்து வருகிறது.. அதனால், பல்வேறு நாடுகளில் பல்வேறு கட்டுப்பாடுகளை அறிவிக்கப்பட்டு வருகின்றன. இந்தியாவிலும் ஓமிக்ரான் வைரஸ் பாதிப்பு கண்டறியப்பட்டுள்ளதாக மத்திய அரசு இன்றைய தினம் அறிவித்துள்ளது பெரும் அதிர்ச்சியை தந்து வருகிறது. கர்நாடகாவில் 2 பேருக்கு இந்த புதிய ஓமிக்ரான் வைரஸ் பாதிப்பு கண்டறியப்பட்டுள்ளதாக அறிவிக்கப்பட்டுள்ளது.

பாதிப்பு
2 பேருமே லேசான பாதிப்பு மட்டுமே உள்ளதாகவும் அறிகுறிகளும் கூட தீவிரமாக இல்லை என்றும் மத்திய அரசு கூறியிருந்தாலும், இது கவலையை ஏற்படுத்தி வருகிறது. ஒமிக்ரான் கண்டறியப்பட்ட 2 பேரில் ஒருவர் வெளிநாட்டை சேர்ந்தவர் என்றும் இன்னொருவர் பெங்களூரை சேர்ந்தவர் என்றும் தெரிவிக்கப்பட்டது. இதையடுத்து, அவர்களுடன் தொடர்பில் இருந்தவர்களை கண்டறிந்து அவர்கள் அனைவருமே தனிமைப்படுத்தப்பட்டனர்... பலருக்கு டெஸ்ட் நடந்து வருகிறது...

அச்சம்
இந்தியாவை போலவே பல்வேறு நாடுகளுக்கும் இந்த வைரஸ் பரவ தொடங்கியுள்ளது. இதனால் உலகம் முழுவதுமுள்ள அரசுகள், தொற்று பாதித்த நாடுகளுடனான விமான சேவையை உடனடியாக ரத்து செய்துள்ளன. இதைதவிர தற்போது மற்றொரு தகவலும் வெளியாகி உள்ளது.. உலகம் முழுவதும் மொத்தம் 29 நாடுகளில் ஒமிக்ரான் வைரஸ் பரவி 373 பேருக்கு பாதிப்பு ஏற்படுத்தி உள்ளதாக கூறப்படுகிறது.. அந்த அளவுக்கு இதன் வேகம் அதிகரித்துள்ளதாக கணக்கிடப்படுகிறது.

29 நாடுகள்
இவற்றில் தென்ஆப்பிரிக்கா, நெதர்லாந்து, டென்மார்க், ஆஸ்திரேலியா, இங்கிலாந்து, ஜெர்மனி, ஜப்பான் உள்ளிட்ட நாடுகளில் முதலில் பாதிப்பு கண்டுபிடிக்கப்பட்டது.. இந்த லிஸ்ட்டில் தற்போது கானா, நைஜீரியா, நார்வே, சவுதி அரேபியா மற்றும் தென்கொரியா உள்ளிட்ட நாடுகளிலும் பரவல் ஏற்பட்டு உள்ளது. ஆக மொத்தம் உலகம் முழுவதும் 29 நாடுகளில் பரவிய ஒமிக்ரான் பாதிப்பு ஏற்பட்டுள்ளது மற்ற நாடுகளுக்கும் அச்சத்தை தந்து வருகிறது.
-
2020ல் 10 லட்சத்திற்கு வாங்கியிருந்தால் இன்று1.7 கோடி ரூபாய்.. இந்தியன் வங்கி மேஜிக் -
விஜய் சேதுபதிக்கு கடன்! 25 லட்சத்தை வாரி வழங்கிய ஆதவ் அர்ஜுனா.. பிரமாண பத்திரத்தில் கசிந்த ரகசியம் -
மூட்டை மூட்டையாக போய் தங்கத்தை அடகு வைக்கும் மக்கள்.. வெளியான ஷாக் தகவல்.. இப்படி ஒரு காரணமா? -
பத்திரப்பதிவில் இன்று முதல் புதிய ரூல்ஸ்! அதிகரிக்கும் சொத்து பதிவு செலவு! கலங்கும் நடுத்தர மக்கள் -
தமிழ் புத்தாண்டு ராசி பலன்: அஷ்டமசனியில் அதிர்ஷ்டத்தை அள்ளும் சிம்ம ராசி.. காதலில் வெற்றி கன்ஃபார்ம் -
சென்னையில் ரூ.36 கோடி கோடிக்கு வீடு வாங்கிய நகை கடைக்காரர்.. அதுவும் இந்த ஏரியாவில்..!! -
33 கேள்விகளுடன் ஒவ்வொரு வீட்டிற்கும்.. நேரடியாகவே வரும் அதிகாரிகள்.. நாம் என்ன செய்ய வேண்டும்? -
திமுக சிங்கிள் மெஜாரிட்டி! அதிமுகவிற்கு எதிர்க்கட்சி அந்தஸ்தே கிடைக்காது? சர்வேவில் கவனிச்சீங்களா -
எதிர்நீச்சல் சீரியல் ராணா யார் தெரியுமா? இத்தனை படங்களில் நடித்திருக்கிறாரா? இனி தான் சம்பவமே இருக்கு -
சென்னை சென்ட்ரல் -கோவை வந்தே பாரத்... தங்க முட்டை போடும் வாத்து.. ஒப்புக்கொண்ட ரயில்வே? -
ஏப்ரல் 1ம் தேதியான இன்று சம்பளம், கடன் எதுவுமே சாத்தியமில்லை... மக்கள் அறிய வேண்டிய உண்மை -
வருமான வரி படிவம் வெளியீடு.. மாத சம்பளம் வாங்குவோர், சிறு வணிகர்கள்.. அறிய வேண்டியவை












Click it and Unblock the Notifications